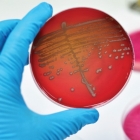

Uma das principais causas de óbito nas emergências e Unidades de Terapia Intensivo, a sepse ainda é uma síndrome desconhecida pelo grande público. Segundo o Instituto Latino Americano de Sepse (ILAS), a mortalidade dos casos chega a 65% no Brasil. No mundo são aproximadamente 24 mil mortes por ano.
A sepse é uma síndrome complexa, constituída por uma série de manifestações graves do organismo em resposta a uma infecção. Essa infecção pode estar presente em apenas um órgão, porém é capaz de provocar um processo de resposta tão intenso que gera disfunções que afetam todo o organismo.
O Hospital São Lucas da PUCRS possui um protocolo de diagnóstico e tratamento precoce de sepse desde junho de 2011. “Todos os colaboradores da enfermagem quando iniciam sua trajetória profissional no HSL são capacitados para reconhecer sinais de Sepse e proceder a abertura do protocolo e manejo. Além disso, também realizamos treinamentos com outros colaboradores como médicos, nutricionistas, acadêmicos e outros” explica Ana Paula Amestoy, enfermeira responsável pelo gerenciamento do Protocolo de Sepse, no Serviço de Controle de Infecção.
Qualquer tipo de infecção pode se tornar uma sepse. Os cuidados de prevenção são os relacionados aos mesmos cuidados de saúde no geral. No Brasil, a sepse é a maior causadora de óbitos, ultrapassando o infarto do miocárdio e alguns tipos de câncer. Segundo especialistas, isso se dá pelo difícil acesso da população ao sistema de saúde, associado ao perfil de patologias crônicas, imunológicas e resistência antimicrobiana.
Os casos mais graves são chamados de choque séptico, no qual o paciente apresenta uma hipotensão que não responde ao volume que é administrado, sendo necessário iniciar com drogas vasoativas. Esses casos possuem prognóstico mais reservado. Pacientes neste estágio representam 25% do total de paciente com abertura de protocolo no HSL. A mortalidade por choque séptico chega a 56%, enquanto a da sepse, mais branda, é de 23% na instituição.
De acordo com dados de um estudo epidemiológico brasileiro, aproximadamente 400 mil pacientes apresentam sepse grave anualmente. Eles são os responsáveis pela ocupação de cerca de 25% dos leitos das unidades de terapia intensiva (UTIs) do país.
A rapidez na identificação e no tratamento da síndrome está diretamente relacionada ao melhor prognóstico do paciente, reduzindo o tempo de permanência do paciente no hospital.
Dia Mundial da Sepse
Desde 2015, o Instituto Latino Americano de Sepse instituiu o dia 13 de setembro como o Dia Mundial da Sepse.